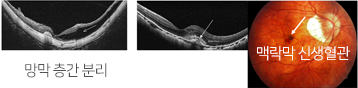

진료과목
망막질환 (고도근시)
고도근시
고도근시란 쉽게 말해서 근시가 심한 것을 말합니다.
성장기에 눈이 럭비공처럼 앞뒤로 길어지면서 근시가 발생하며,
심한 경우에 맥락막과 망막조직이 늘어나면서 얇아져 구조으로
약해지며 시기능의 장애를 동반하고 여러가지 질환이 발생하게
됩니다.
고도근시는 굴절력(안경 돗수) -6.0디옵터 이상, 또는 눈의
앞뒤길이가 26mm 이상인 경우를 의미하며 굴절력 -9.0디옵터
이상을 초고도근시라고 합니다.
병적 근시
심한 경우 병적 근시를 유발하여 이는 황반을 포함한 안구
뒷부분의 확장인 후포도종과 점진적인 맥락망막변성 소견 등
퇴행성 변화를 동반 합니다.

병적 근시 합병증
망막 층간 분리 및 맥락막 신생 혈관이 발생 할 수 있으며 이는
갑작스런 시력 저하를 유발합니다.
적절한 치료로 더 이상의 시력 저하를 막는 것이 최선의 치료
입니다.
조은안과는 이러한 질환의 진단에 이용 되는 망막 단층 촬영기
및 형광 안저 카메라를 서울의 유명한 대학 병원급에서 사용하는
장비로 보유하고 있습니다.
주변부 망막변성
고도근시에서 맥락망막변화는 주변부 망막에도 발생합니다.
망막열공이 흔하게 발생하며 망막박리의 위험성을 높일 수
있습니다. 망막박리는 시력소실이 가능한 무서운 질환이므로
망막박리가 발생하기 전 미리 예방적 치료가 필요합니다. 예방적
치료로 ‘장벽 레이저광응고술’ 을 통해 변성 부위 주변의 정상
망막에 레이저를 조사하여 망막이 아래조직과 단단히 붙게 되고
망막박리의 위험성을 낮출 수 있습니다.
망막 열공과 레이져 치료
주변부 망막 질환이 중심에서 멀리 위치할 수록 발견 하기
어려우며 숙련된이 필요합니다.
조은 안과에서는 주변부 망막 촬영이 가능한 광각 안저 촬영
장비를 영동 지역 최초로 도입하였고, 레이져 치료 또한 통증의
감소 및 치료 시간 단축이 가능한 저통증 패턴 레이져 치료기를
영동지역 최초로 도입하였습니다.

후유리체박리
눈속을 채우고 있는 투명한 젤리 성분의 유리체는 망막과
단단하게 붙어있지만 나이가 증가함에 따라 젤리에서 액체로
변하게 되고 망막과 분리 되는데 이를 후유리체박리라고
합니다.
고도근시안에서는 후유리체박리가 조기에, 광범위하게 발생할
수 있으며 광시증과 날파리증이 동반될 수 있습니다.
갑자기 후유리체박리가 진행되는 경우 망막열공이 유발되면서
유리체출혈이 동반되기도 합니다


